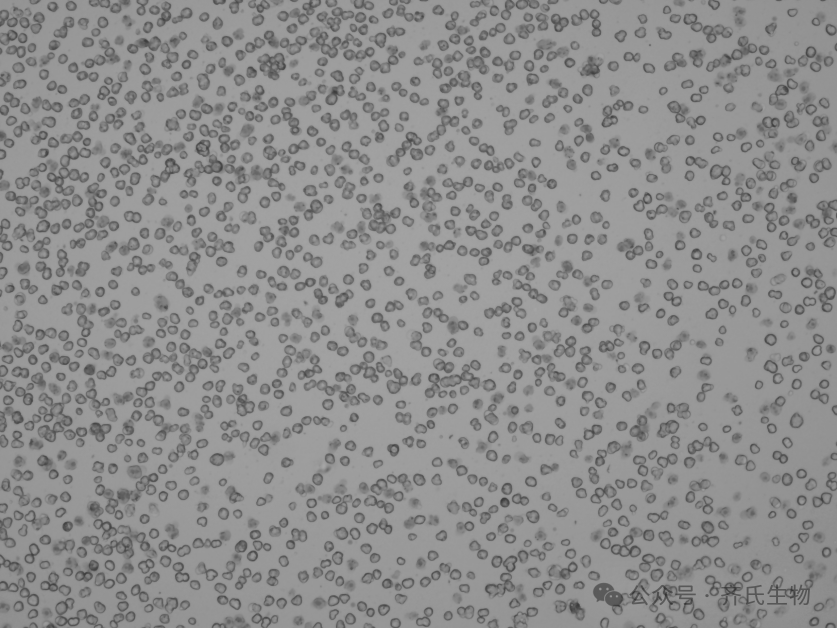
图片

16 年
手机商铺
技术资料/正文
94 人阅读发布时间:2025-05-08 07:02
(来源:齐氏生物 研发中心)
一、产品特色
· 物种覆盖:提供人、猴、犬、大鼠、小鼠、猪、牛、鸭、鸡、鱼等健康及疾病模型肝细胞,支持人用药、宠物药、兽药等多领域研究。
· 活性保障:冻存技术优化,复苏后细胞活性≥85%,贴壁率超90%,支持长期稳定实验。
· 试剂配套:专用培养基、冻存液、鼠尾胶原、基质胶、分离/鉴定试剂盒。
· 特色服务:孔板新鲜细胞,江浙沪地区提供2-4小时,"lab-to-lab"配送服务。
二、产品类型
☆ 悬浮肝实质细胞
悬浮肝细胞一般用于代谢稳定性研究或代谢物谱研究,在最开始的4-6h内效果最佳。



贴壁肝细胞一般用于酶诱导研究、药物细胞毒性研究、慢代谢药物的代谢稳定性或产物推断研究。



三、保存应用
客户可以根据自己的需求选择新鲜或者冻存的原代细胞,如是新鲜原代细胞,客户收到细胞后应立即将其放入CO2细胞培养箱内静置后2-3h,再进行后续的实验操作。如是冻存细胞,客户收到细胞后应立即将其放入液氮、-80℃冰箱或立即进行复苏。
齐氏生物深耕原代细胞领域16年,专属客户经理+技术支持,24h 售后响应。